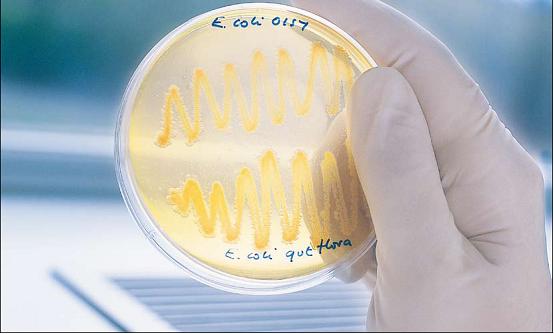

前言
Astell Scientific公司是英国的一家居领先地位的消毒设备制造商,该公司有70多年的经验,其产品被世界医药领域的知名公司采用。“消毒设备”和“消毒器”两个词的含义相同,可以互换。“消毒设备”用于实验室,而“消毒器”则更普遍地用于医药应用领域。
所有在微生物学或相关领域,包括医疗和消毒服务领域工作的科学家和技术人员都理解消毒的必要性。实验室设备需要消毒以防止污染,外科仪器和敷料需要消毒以防止感染,培养基需要消毒以防止得出不准确的结果,废弃物需要消毒以防止病原体危险。
比较难理解的是消毒到底指什么。消毒的最佳定义是从统计学上完全杀死所有的微生物,包括耐受力最强的细菌和孢子。实际上这种条件难以达到,甚至更难以证明。虽然有很多有机和无机化学品可以杀死微生物,但是这些化学品并不是100%的有效,并且经常会遗留不需要的,甚至是有毒的残留物。紫外线和离子辐射也是有效的生物杀灭手段,但是并不能保证完全杀除。
高温蒸汽消毒法
既然消毒是绝对必要的要求,当前实验室中的科学家就转向通过蒸汽热量进行消毒。
随着其周围温度的升高,微生物会变得更加活跃。但是到
高温消毒器怎样工作?
有效的高温消毒器中必须有干燥的饱和蒸汽。为达到这一目标,就必须去除消毒对象以及消毒室中的空气。这可以通过几种途径实现,但最有效的去除空气的方法是通过真空系统。当所有的空气去除之后,消毒室中的温度会在控制下随着压力的增加而上升,直到达到预先选择的温度为止。要达到一般的


Power Panel的显示功能可对真空度、压力脉冲、干燥和冷却进行简单设置
对消毒对象进行消毒只是一个方面。遵守GMP、UKAS以及类似的质量保证程序也同样重要,而这就需要证明已经达到了消毒的效果。对于完全消毒,高温消毒器以及消毒对象的所有部分都必须要达到规定温度,而这就要通过高温消毒器中的自动装置对温度和消毒过程中保持该温度的时间进行监视和记录从而予以确认。
贝加莱公司的解决方案
当Astell公司决定扩大其在方形和矩形截面消毒器市场的份额时,他们意识到需要为其产品配备在当前控制技术中居领先地位的新控制系统,而基于贝加莱公司控制盘的自动化系统提供了一种理想的解决方案。这样两个有多年经验的公司开始合作生产一种用户友好的、完全自动化的控制系统。

Astell公司的矩形截面高温消毒器。消毒对象从未消毒的外部区域放入消毒口,然后开始消毒进程
该控制系统的核心是一块PowerPanel 220面板,该面板配备一块
Astell公司的技术总监Graham Scarr说:“新的控制系统比以前的系统具有更好的精确性、可靠性和柔性,我们现在可以向客户提供众多功能(例如数据存档、Fo控制以及设置特定周期等),而以前的产品并没有这些功能。这样我们就不仅有机会增加市场份额,而且还能够进入新领域,如医药领域,在这些领域中准确并且方便地确认消毒效果是非常重要的”。

